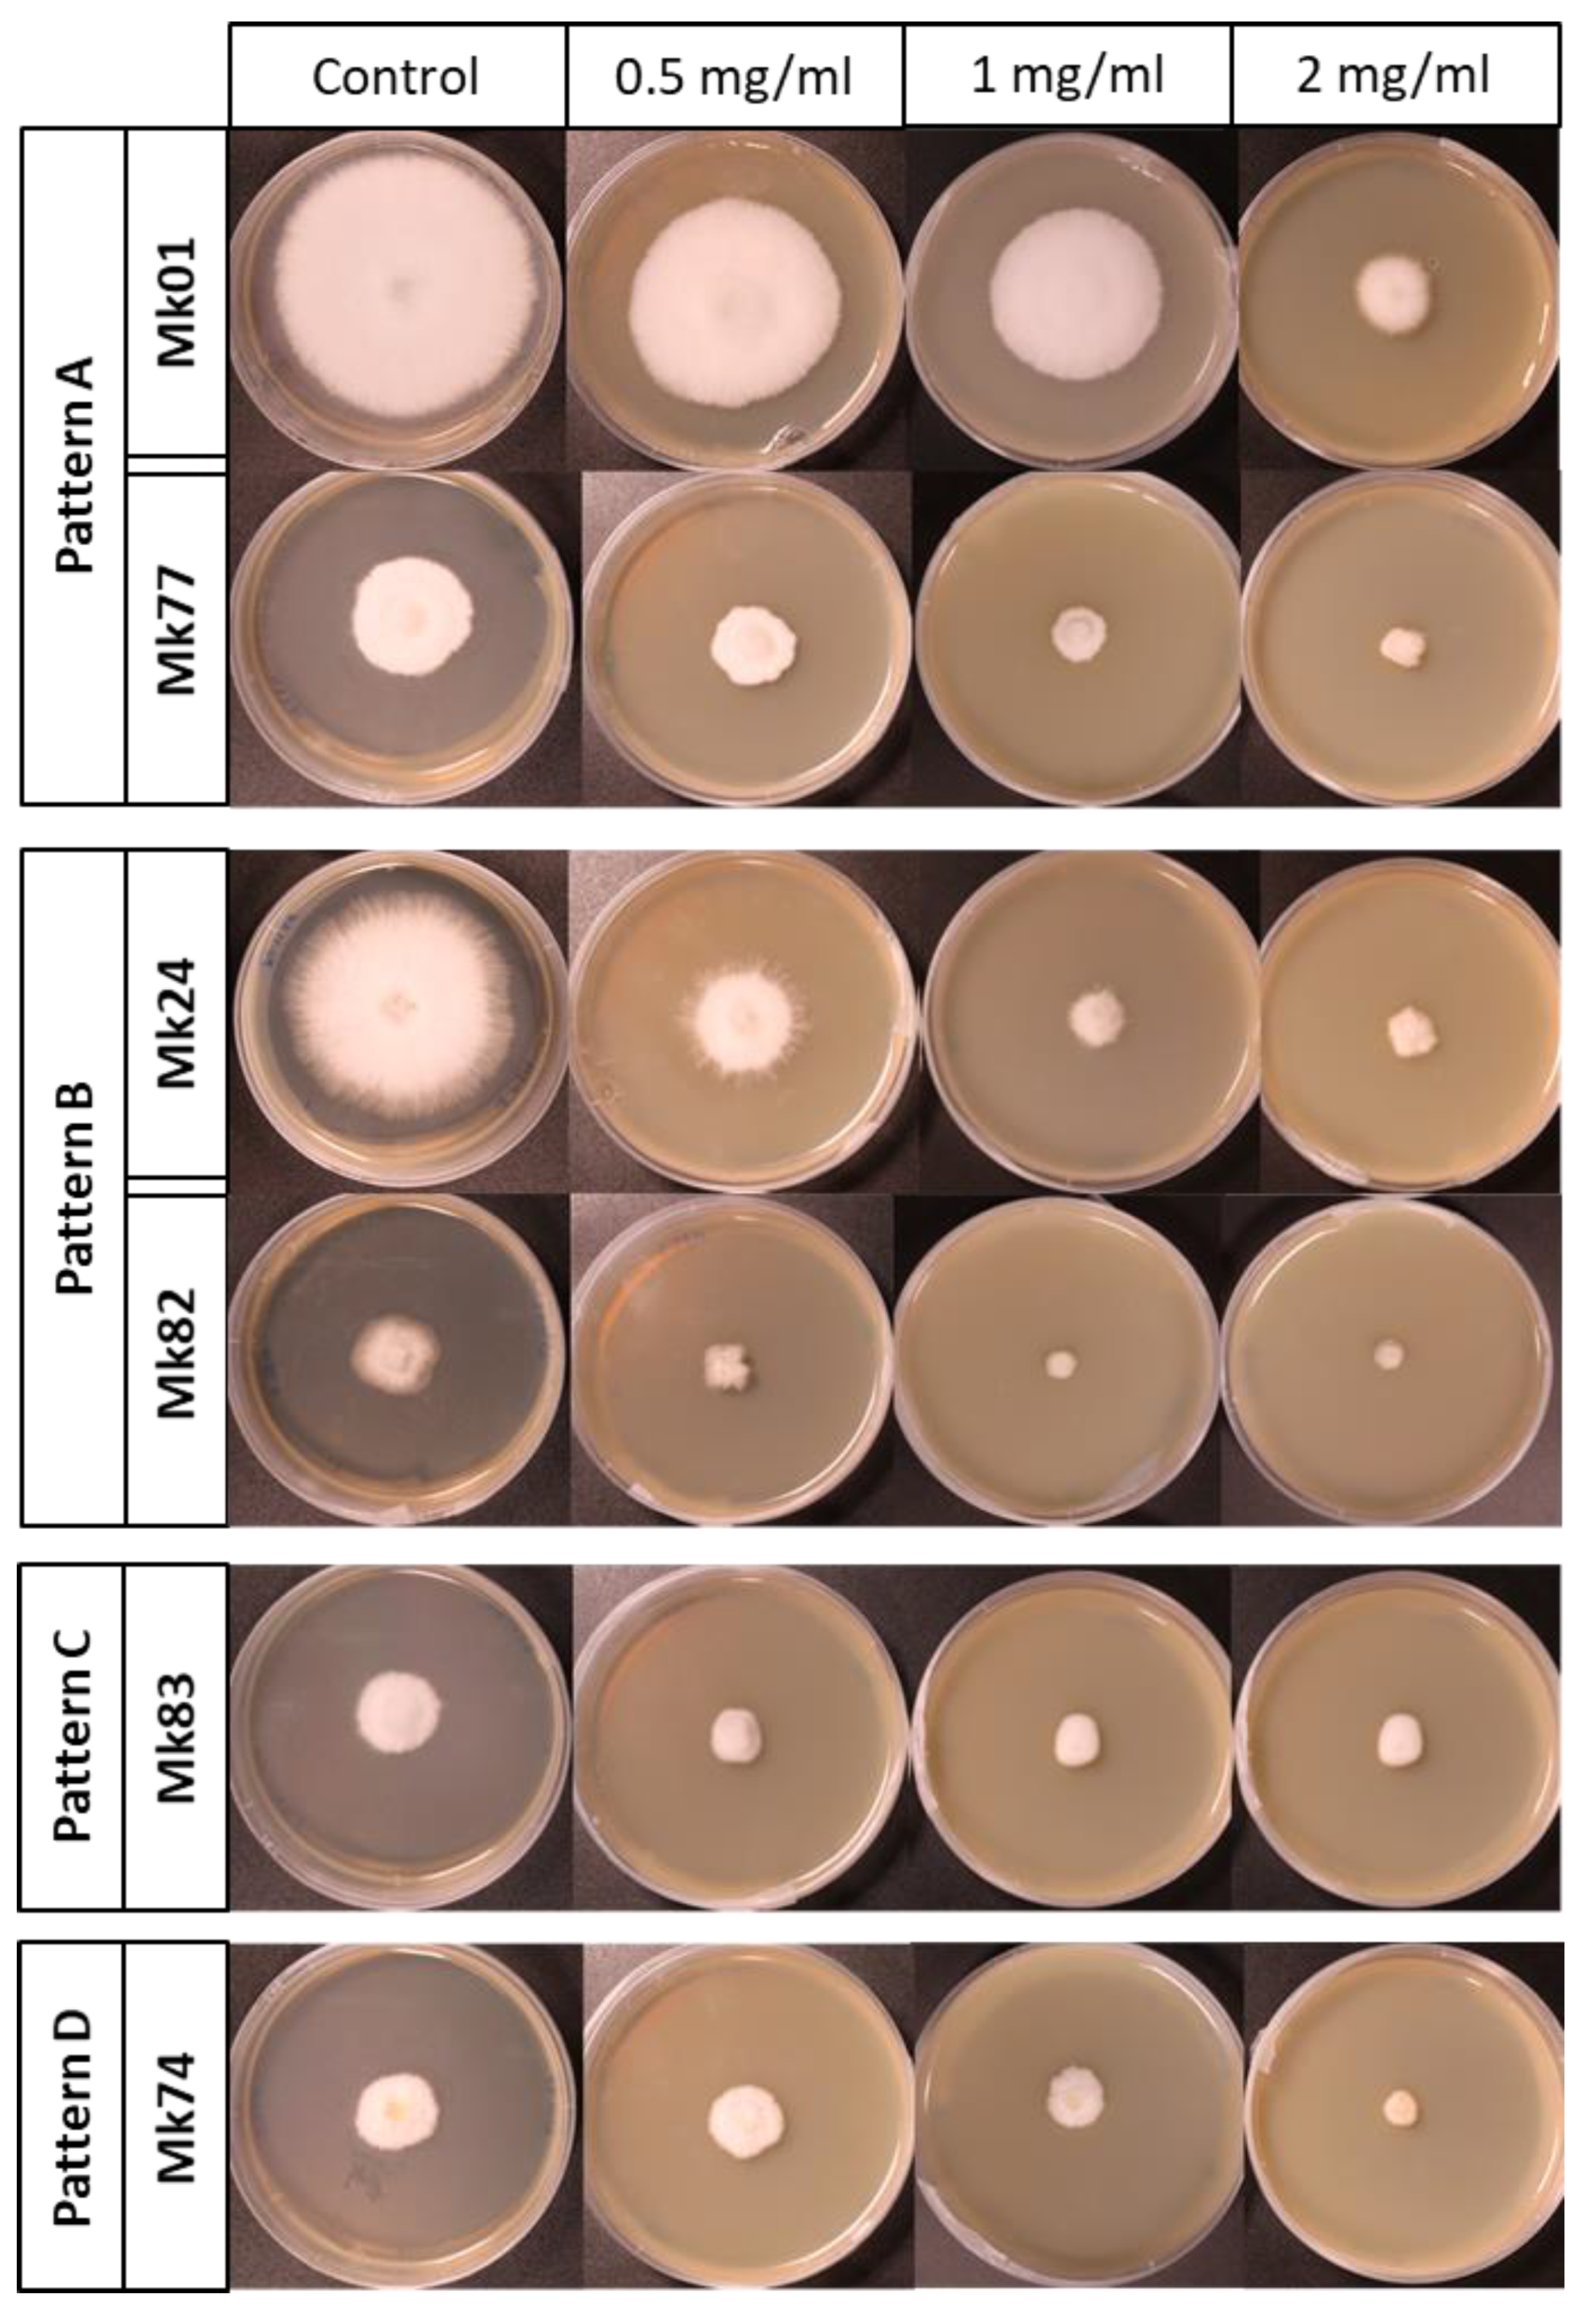
Jof 07 00862 g005

Strain Degeneration in Pleurotus ostreatus: A Genotype Dependent Oxidative Stress Process Which Triggers Oxidative Stress, Cellular Detoxifying and Cell Wall Reshaping Genes
Abstract
1. Introduction
2. Materials and Methods
2.1. Fungal Strains and Growth Conditions
2.2. RNA Extraction, Library Construction, and Sequencing
2.3. Analysis of Sequencing Data
2.4. SNPs and Crossover Detection
2.5. Correlation Analysis between Growth Rate and Gene Expression (RPKMs)
2.6. Functional Analysis of Genes
2.7. RT-qPCR Analysis
2.8. ROS Detection Assay
2.9. Lipid Peroxidation Assay
2.10. Chitosan Treatments
2.11. Protein Purification and Immunoblot Analysis
3. Results
3.1. Growth Rate as a Feature to Identify Monokaryons
3.2. Fast-Growing Monokaryons Are Higher Biomass Producers
3.3. RNA Sequence Analysis Allows Detection of SNPs and Crossover Locations and Reveals Differences between F- and S-Subpopulations
3.4. Different Gene Expression of the F- and S-Subpopulations
3.4.1. Validation of DEGs by RT-qPCR
3.4.2. Gene Expression Profiles Explain Correlations between Genotype and Phenotype in Monokaryons Belonging to F- and S-Subpopulations
3.5. In Situ Detection of Superoxide Radicals and Hydrogen Peroxide in Monokaryons Suggest Oxidative Stress
3.6. Assessment of Lipid Peroxidation by MDA Levels in Monokaryons of F- and S-Subpopulations
3.7. Monokaryons of the F-Subpopulation Are More Sensitive to Chitosan
3.8. Effect of Chitosan Treatments on Some Genes Upregulated in Monokaryons of the F- and S-Subpopulations
3.9. Analysis of Mitogen-Activated Protein Kinase (MAPK) Signalling Pathways in Monokaryons of the F- and S-Subpopulations
4. Discussions
Supplementary Materials
Author Contributions
Funding
Institutional Review Board Statement
Informed Consent Statement
Data Availability Statement
Conflicts of Interest
References
- Xiong, C.; Xia, Y.; Zheng, P.; Wang, C. Increasing oxidative stress tolerance and subculturing stability of Cordyceps militaris by overexpression of a glutathione peroxidase gene. Appl. Microbiol. Biotechnol. 2013, 97, 2009–2015. [Google Scholar] [CrossRef]
- Li, L.; Hu, X.; Xia, Y.; Xiao, G.; Zheng, P.; Wang, C. Linkage of oxidative stress and mitochondrial dysfunctions to spontaneous culture degeneration in aspergillus nidulans. Mol. Cell. Proteom. 2014, 13, 449–461. [Google Scholar] [CrossRef] [PubMed]
- Wang, C.; Butt, T.M.; St. Leger, R.J. Colony sectorization of Metarbizium anisopliae is a sign of ageing. Microbiology 2005, 151, 3223–3236. [Google Scholar] [CrossRef] [PubMed]
- Chen, X.; Zhang, Z.; Liu, X.; Cui, B.; Miao, W.; Cheng, W.; Zhao, F. Characteristics Analysis Reveals the Progress of Volvariella volvacea Mycelium Subculture Degeneration. Front. Microbiol. 2019, 10, 2045. [Google Scholar] [CrossRef] [PubMed]
- Betteridge, D.J. What is oxidative stress? Metabolism 2000, 49, 3–8. [Google Scholar] [CrossRef]
- Perrone, G.G.; Tan, S.X.; Dawes, I.W. Reactive oxygen species and yeast apoptosis. Biochim. Biophys. Acta Mol. Cell Res. 2008, 1783, 1354–1368. [Google Scholar] [CrossRef] [PubMed]
- Theopold, U. Developmental biology: A bad boy comes good. Nature 2009, 461, 486–487. [Google Scholar] [CrossRef]
- Bigarella, C.L.; Liang, R.; Ghaffari, S. Stem cells and the impact of ROS signaling. Development 2014, 141, 4206–4218. [Google Scholar] [CrossRef]
- Jazwinski, S.M. The retrograde response: When mitochondrial quality control is not enough. Biochim. Biophys. Acta Mol. Cell Res. 2013, 1833, 400–409. [Google Scholar] [CrossRef] [PubMed]
- Ng, S.; De Clercq, I.; Van Aken, O.; Law, S.R.; Ivanova, A.; Willems, P.; Giraud, E.; Van Breusegem, F.; Whelan, J. Anterograde and retrograde regulation of nuclear genes encoding mitochondrial proteins during growth, development, and stress. Mol. Plant 2014, 7, 1075–1093. [Google Scholar] [CrossRef] [PubMed]
- Da Cunha, F.M.; Torelli, N.Q.; Kowaltowski, A.J. Mitochondrial Retrograde Signaling: Triggers, Pathways, and Outcomes. Oxid. Med. Cell. Longev. 2015, 2015, 1–10. [Google Scholar] [CrossRef] [PubMed]
- Jiang, J.C.; Stumpferl, S.W.; Tiwari, A.; Qin, Q.; Rodriguez-Quiñones, J.F.; Jazwinski, S.M. Identification of the target of the retrograde response that mediates replicative lifespan extension in Saccharomyces cerevisiae. Genetics 2016, 204, 659–673. [Google Scholar] [CrossRef]
- Kupsco, A.; Schlenk, D. Oxidative Stress, Unfolded Protein Response, and Apoptosis in Developmental Toxicity. Int. Rev. Cell Mol. Biol. 2015, 317, 1–66. [Google Scholar] [CrossRef]
- Lindholm, D.; Korhonen, L.; Eriksson, O.; Kõks, S. Recent insights into the role of unfolded protein response in ER stress in health and disease. Front. Cell Dev. Biol. 2017, 5, 48. [Google Scholar] [CrossRef] [PubMed]
- Guerra-Moreno, A.; Ang, J.; Welsch, H.; Jochem, M.; Hanna, J. Regulation of the unfolded protein response in yeast by oxidative stress. FEBS Lett. 2019, 593, 1080–1088. [Google Scholar] [CrossRef]
- Chong, W.C.; Shastri, M.D.; Eri, R. Endoplasmic reticulum stress and oxidative stress: A vicious nexus implicated in bowel disease pathophysiology. Int. J. Mol. Sci. 2017, 18, 771. [Google Scholar] [CrossRef] [PubMed]
- Amen, O.M.; Sarker, S.D.; Ghildyal, R.; Arya, A. Endoplasmic reticulum stress activates unfolded protein response signaling and mediates inflammation, obesity, and cardiac dysfunction: Therapeutic and molecular approach. Front. Pharmacol. 2019, 10, 997. [Google Scholar] [CrossRef]
- Jazwinski, S.M. Mitochondria to nucleus signaling and the role of ceramide in its integration into the suite of cell quality control processes during aging. Ageing Res. Rev. 2015, 23, 67–74. [Google Scholar] [CrossRef] [PubMed]
- Guaragnella, N.; Coyne, L.P.; Chen, X.J.; Giannattasio, S. Mitochondria-cytosol-nucleus crosstalk: Learning from Saccharomyces cerevisiae. FEMS Yeast Res. 2018, 18, foy088. [Google Scholar] [CrossRef]
- Martínez-Soto, D.; Ruiz-Herrera, J. Functional analysis of the MAPK pathways in fungi. Rev. Iberoam. Micol. 2017, 34, 192–202. [Google Scholar] [CrossRef]
- Hagiwara, D.; Sakamoto, K.; Abe, K.; Gomi, K. Signaling pathways for stress responses and adaptation in Aspergillus species: Stress biology in the post-genomic era. Biosci. Biotechnol. Biochem. 2016, 80, 1667–1680. [Google Scholar] [CrossRef]
- González-Rubio, G.; Fernández-Acero, T.; Martín, H.; Molina, M. Mitogen-activated protein kinase phosphatases (MKPs) in fungal signaling: Conservation, function, and regulation. Int. J. Mol. Sci. 2019, 20, 1709. [Google Scholar] [CrossRef]
- Zadrag-Tecza, R.; Maślanka, R.; Bednarska, S.; Kwolek-Mirek, M. Response mechanisms to oxidative stress in yeast and filamentous fungi. In Stress Response Mechanisms in Fungi: Theoretical and Practical Aspects; Springer: Cham, Switzerland, 2018; pp. 1–34. ISBN 9783030006839. [Google Scholar]
- Gostinčar, C.; Gunde-Cimerman, N. Overview of oxidative stress response genes in selected halophilic fungi. Genes 2018, 9, 143. [Google Scholar] [CrossRef] [PubMed]
- Lazarova, N.; Krumova, E.; Stefanova, T.; Georgieva, N.; Angelova, M. The oxidative stress response of the filamentous yeast Trichosporon cutaneum R57 to copper, cadmium and chromium exposure. Biotechnol. Biotechnol. Equip. 2014, 28, 855–862. [Google Scholar] [CrossRef]
- Mejía-Barajas, J.A.; Montoya-Pérez, R.; Salgado-Garciglia, R.; Aguilera-Aguirre, L.; Cortés-Rojo, C.; Mejía-Zepeda, R.; Arellano-Plaza, M.; Saavedra-Molina, A. Oxidative stress and antioxidant response in a thermotolerant yeast. Braz. J. Microbiol. 2017, 48, 326–332. [Google Scholar] [CrossRef]
- Dbouk, N.H.; Covington, M.B.; Nguyen, K.; Chandrasekaran, S. Increase of reactive oxygen species contributes to growth inhibition by fluconazole in Cryptococcus neoformans. BMC Microbiol. 2019, 19, 1–10. [Google Scholar] [CrossRef] [PubMed]
- Lopez-Moya, F.; Kowbel, D.; Nueda, M.J.; Palma-Guerrero, J.; Glass, N.L.; Lopez-Llorca, L.V. Neurospora crassa transcriptomics reveals oxidative stress and plasma membrane homeostasis biology genes as key targets in response to chitosan. Mol. Biosyst. 2016, 12, 391–403. [Google Scholar] [CrossRef] [PubMed]
- Rabea, E.I.; Badawy, M.E.T.; Stevens, C.V.; Smagghe, G.; Steurbaut, W. Chitosan as antimicrobial agent: Applications and mode of action. Biomacromolecules 2003, 4, 1457–1465. [Google Scholar] [CrossRef]
- Laflamme, P.; Benhamou, N.; Bussières, G.; Dessureault, M. Differential effect of chitosan on root rot fungal pathogens in forest nurseries. Can. J. Bot. 2000, 77, 1460–1468. [Google Scholar] [CrossRef]
- Liu, X.F.; Guan, Y.L.; Yang, D.Z.; Li, Z.; Yao, K. DE Antibacterial action of chitosan and carboxymethylated chitosan. J. Appl. Polym. Sci. 2001, 79, 1324–1335. [Google Scholar] [CrossRef]
- Liu, H.; Du, Y.; Wang, X.; Sun, L. Chitosan kills bacteria through cell membrane damage. Int. J. Food Microbiol. 2004, 95, 147–155. [Google Scholar] [CrossRef]
- Tikhonov, V.E.; Stepnova, E.A.; Babak, V.G.; Yamskov, I.A.; Palma-Guerrero, J.; Jansson, H.B.; Lopez-Llorca, L.V.; Salinas, J.; Gerasimenko, D.V.; Avdienko, I.D.; et al. Bactericidal and antifungal activities of a low molecular weight chitosan and its N-/2(3)-(dodec-2-enyl)succinoyl/-derivatives. Carbohydr. Polym. 2006, 64, 66–72. [Google Scholar] [CrossRef]
- Palma-Guerrero, J.; Jansson, H.B.; Salinas, J.; Lopez-Llorca, L.V. Effect of chitosan on hyphal growth and spore germination of plant pathogenic and biocontrol fungi. J. Appl. Microbiol. 2008, 104, 541–553. [Google Scholar] [CrossRef] [PubMed]
- Ait Barka, E.; Eullaffroy, P.; Clément, C.; Vernet, G. Chitosan improves development, and protects Vitis vinifera L. against Botrytis cinerea. Plant Cell Rep. 2004, 22, 608–614. [Google Scholar] [CrossRef] [PubMed]
- Lafontaine, P.J.; Benhamou, N. Chitosan treatment: An emerging strategy for enhancing resistance of greenhouse tomato plants to infection by Fusarium oxysporum f.sp. radicis-lycopersici. Biocontrol Sci. Technol. 1996, 6, 111–124. [Google Scholar] [CrossRef]
- Trotel-Aziz, P.; Couderchet, M.; Vernet, G.; Aziz, A. Chitosan stimulates defense reactions in grapevine leaves and inhibits development of Botrytis cinerea. Eur. J. Plant Pathol. 2006, 114, 405–413. [Google Scholar] [CrossRef]
- Zakrzewska, A.; Boorsma, A.; Brul, S.; Hellingwerf, K.J.; Klis, F.M. Transcriptional response of Saccharomyces cerevisiae to the plasma membrane-perturbing compound chitosan. Eukaryot. Cell 2005, 4, 703–715. [Google Scholar] [CrossRef]
- Kumar, M.N.V.R.; Muzzarelli, R.A.A.; Muzzarelli, C.; Sashiwa, H.; Domb, A.J. Chitosan chemistry and pharmaceutical perspectives. Chem. Rev. 2004, 104, 6017–6084. [Google Scholar] [CrossRef]
- Palma-Guerrero, J.; Lopez-Jimenez, J.A.; Pérez-Berná, A.J.; Huang, I.C.; Jansson, H.B.; Salinas, J.; Villalaín, J.; Read, N.D.; Lopez-Llorca, L.V. Membrane fluidity determines sensitivity of filamentous fungi to chitosan. Mol. Microbiol. 2010, 75, 1021–1032. [Google Scholar] [CrossRef] [PubMed]
- Oriaran, T.P.; Labosky, P.; Royse, D.J. Lignin degradation capabilities of Pleurotus ostreatus, Lentinula edodes and Phanerochaete chrysosporium. Wood Fiber Sci. 1989, 21, 183–192. [Google Scholar]
- Cohen, R.; Persky, L.; Hadar, Y. Biotechnological applications and potential of wood-degrading mushrooms of the genus Pleurotus. Appl. Microbiol. Biotechnol. 2002, 58, 582–594. [Google Scholar] [CrossRef] [PubMed]
- Marlin, M.; Wolf, A.; Alomran, M.; Carta, L.; Newcombe, G. Nematophagous pleurotus species consume some nematode species but are themselves consumed by others. Forests 2019, 10, 404. [Google Scholar] [CrossRef]
- Borgognone, A.; Castanera, R.; Muguerza, E.; Pisabarro, A.G.; Ramírez, L. Somatic transposition and meiotically driven elimination of an active helitron family in Pleurotus ostreatus. DNA Res. 2017, 24, 103–115. [Google Scholar] [CrossRef] [PubMed]
- Larraya, L.; Peñas, M.M.; Pérez, G.; Santos, C.; Ritter, E.; Pisabarro, A.G.; Ramírez, L. Identification of incompatibility alleles and characterisation of molecular markers genetically linked to the A incompatibility locus in the white rot fungus Pleurotus ostreatus. Curr. Genet. 1999, 34, 486–493. [Google Scholar] [CrossRef]
- Larraya, L.M.; Pérez, G.; Ritter, E.; Pisabarro, A.G.; Ramírez, L. Genetic linkage map of the edible basidiomycete Pleurotus ostreatus. Appl. Environ. Microbiol. 2000, 66, 5290–5300. [Google Scholar] [CrossRef]
- Castanera, R.; Pérez, G.; Omarini, A.; Alfaro, M.; Pisabarro, A.G.; Faraco, V.; Amore, A.; Ramírez, L. Transcriptional and enzymatic profiling of Pleurotus ostreatus laccase genes in submerged and solid-state fermentation cultures. Appl. Environ. Microbiol. 2012, 78, 4037–4045. [Google Scholar] [CrossRef]
- Castanera, R.; Pérez, G.; López, L.; Sancho, R.; Santoyo, F.; Alfaro, M.; Gabaldón, T.; Pisabarro, A.G.; Oguiza, J.A.; Ramírez, L. Highly expressed captured genes and cross-kingdom domains present in Helitrons create novel diversity in Pleurotus ostreatus and other fungi. BMC Genom. 2014, 15, 1071. [Google Scholar] [CrossRef]
- Alfaro, M.; Castanera, R.; Lavín, J.L.; Grigoriev, I.V.; Oguiza, J.A.; Ramírez, L.; Pisabarro, A.G. Comparative and transcriptional analysis of the predicted secretome in the lignocellulose-degrading basidiomycete fungus Pleurotus ostreatus. Environ. Microbiol. 2016, 18, 4710–4726. [Google Scholar] [CrossRef]
- Peñas, M.M.; Azparren, G.; Domínguez, Á.; Sommer, H.; Ramírez, L.; Pisabarro, A.G. Identification and functional characterisation of ctr1, a Pleurotus ostreatus gene coding for a copper transporter. Mol. Genet. Genom. 2005, 274, 402–409. [Google Scholar] [CrossRef]
- Pérez, G.; Pangilinan, J.; Pisabarro, A.G.; Ramírez, L. Telomere organization in the ligninolytic basidiomycete Pleurotus ostreatus. Appl. Environ. Microbiol. 2009, 75, 1427–1436. [Google Scholar] [CrossRef]
- Larraya, L.M.; Idareta, E.; Arana, D.; Ritter, E.; Pisabarro, A.G.; Ramírez, L. Quantitative trait loci controlling vegetative growth rate in the edible basidiomycete Pleurotus ostreatus. Appl. Environ. Microbiol. 2002, 68, 1109–1114. [Google Scholar] [CrossRef] [PubMed][Green Version]
- Larraya, L.M.; Alfonso, M.; Pisabarro, A.G.; Ramírez, L. Mapping of genomic regions (quantitative trait loci) controlling production and quality in industrial cultures of the edible basidiomycete Pleurotus ostreatus. Appl. Environ. Microbiol. 2003, 69, 3617–3625. [Google Scholar] [CrossRef]
- Larraya, L.M.; Pérez, G.; Peñas, M.M.; Baars, J.J.P.; Mikosch, T.S.P.; Pisabarro, A.G.; Ramírez, L. Molecular karyotype of the white rot fungus Pleurotus ostreatus. Appl. Environ. Microbiol. 1999, 65, 3413–3417. [Google Scholar] [CrossRef] [PubMed]
- Castanera, R.; López-Varas, L.; Borgognone, A.; LaButti, K.; Lapidus, A.; Schmutz, J.; Grimwood, J.; Pérez, G.; Pisabarro, A.G.; Grigoriev, I.V.; et al. Transposable Elements versus the Fungal Genome: Impact on Whole-Genome Architecture and Transcriptional Profiles. PLoS Genet. 2016, 12, e1006108. [Google Scholar] [CrossRef] [PubMed]
- Ravi Kumar, M.N.V. A review of chitin and chitosan applications. React. Funct. Polym. 2000, 46, 1–27. [Google Scholar] [CrossRef]
- Grigoriev, I.V.; Nikitin, R.; Haridas, S.; Kuo, A.; Ohm, R.; Otillar, R.; Riley, R.; Salamov, A.; Zhao, X.; Korzeniewski, F.; et al. MycoCosm portal: Gearing up for 1000 fungal genomes. Nucleic Acids Res. 2014, 42, D699–D704. [Google Scholar] [CrossRef]
- Dobin, A.; Davis, C.A.; Schlesinger, F.; Drenkow, J.; Zaleski, C.; Jha, S.; Batut, P.; Chaisson, M.; Gingeras, T.R. STAR: Ultrafast universal RNA-seq aligner. Bioinformatics 2013, 29, 15–21. [Google Scholar] [CrossRef]
- Altschul, S.F.; Madden, T.L.; Schäffer, A.A.; Zhang, J.; Zhang, Z.; Miller, W.; Lipman, D.J. Gapped BLAST and PSI-BLAST: A new generation of protein database search programs. Nucleic Acids Res. 1997, 25, 3389–3402. [Google Scholar] [CrossRef] [PubMed]
- Alkan, C.; Kidd, J.M.; Marques-Bonet, T.; Aksay, G.; Antonacci, F.; Hormozdiari, F.; Kitzman, J.O.; Baker, C.; Malig, M.; Mutlu, O.; et al. Personalized copy number and segmental duplication maps using next-generation sequencing. Nat. Genet. 2009, 41, 1061–1067. [Google Scholar] [CrossRef]
- Depristo, M.A.; Banks, E.; Poplin, R.; Garimella, K.V.; Maguire, J.R.; Hartl, C.; Philippakis, A.A.; Del Angel, G.; Rivas, M.A.; Hanna, M.; et al. A framework for variation discovery and genotyping using next-generation DNA sequencing data. Nat. Genet. 2011, 43, 491–501. [Google Scholar] [CrossRef]
- Benjamini, Y.; Yekutieli, D. The control of the false discovery rate in multiple testing under dependency. Ann. Stat. 2001, 29, 1165–1188. [Google Scholar] [CrossRef]
- Robinson, M.D.; McCarthy, D.J.; Smyth, G.K. edgeR: A Bioconductor package for differential expression analysis of digital gene expression data. Bioinformatics 2009, 26, 139–140. [Google Scholar] [CrossRef]
- Conesa, A.; Götz, S. Blast2GO: A comprehensive suite for functional analysis in plant genomics. Int. J. Plant Genom. 2008, 2008. [Google Scholar] [CrossRef] [PubMed]
- Livak, K.J.; Schmittgen, T.D. Analysis of relative gene expression data using real-time quantitative PCR and the 2−ΔΔCT method. Methods 2001, 25, 402–408. [Google Scholar] [CrossRef]
- Castanera, R.; López-Varas, L.; Pisabarro, A.G.; Ramíre, L. Validation of reference genes for transcriptional analyses in Pleurotus ostreatus by using reverse transcription-quantitative PCR. Appl. Environ. Microbiol. 2015, 81, 4120–4129. [Google Scholar] [CrossRef] [PubMed]
- Hodges, D.M.; DeLong, J.M.; Forney, C.F.; Prange, R.K. Improving the thiobarbituric acid-reactive-substances assay for estimating lipid peroxidation in plant tissues containing anthocyanin and other interfering compounds. Planta 1999, 207, 604–611. [Google Scholar] [CrossRef]
- Torralba, S.; Pisabarro, A.G.; Ramírez, L.; Ramirez, L. Immunofluorescence Microscopy of the Microtubule Cytoskeleton during Conjugate Division in the Dikaryon Pleurotus ostreatus N001. Mycologia 2004, 96, 41. [Google Scholar] [CrossRef] [PubMed]
- Chiu, J.; Tactacan, C.M.; Tan, S.X.; Lin, R.C.Y.; Wouters, M.A.; Dawes, I.W. Cell cycle sensing of oxidative stress in Saccharomyces cerevisiae by oxidation of a specific cysteine residue in the transcription factor Swi6p. J. Biol. Chem. 2011, 286, 5204–5214. [Google Scholar] [CrossRef]
- Sonnenberg, A.S.M.; Gao, W.; Lavrijssen, B.; Hendrickx, P.; Sedaghat-Tellgerd, N.; Foulongne-Oriol, M.; Kong, W.S.; Schijlen, E.G.W.M.; Baars, J.J.P.; Visser, R.G.F. A detailed analysis of the recombination landscape of the button mushroom Agaricus bisporus var. bisporus. Fungal Genet. Biol. 2016, 93, 35–45. [Google Scholar] [CrossRef]
- Prelich, G. Gene overexpression: Uses, mechanisms, and interpretation. Genetics 2012, 190, 841–854. [Google Scholar] [CrossRef] [PubMed]
- Suparmin, A.; Kato, T.; Takemoto, H.; Park, E.Y. Metabolic comparison of aerial and submerged mycelia formed in the liquid surface culture of Cordyceps militaris. Microbiologyopen 2019, 8, e00836. [Google Scholar] [CrossRef]
- Cárdenas-Monroy, C.A.; Pohlmann, T.; Piñón-Zárate, G.; Matus-Ortega, G.; Guerra, G.; Feldbrügge, M.; Pardo, J.P. The mitochondrial alternative oxidase Aox1 is needed to cope with respiratory stress but dispensable for pathogenic development in Ustilago maydis. PLoS ONE 2017, 12, e0173389. [Google Scholar] [CrossRef] [PubMed]
- Turk, H. Chitosan-induced enhanced expression and activation of alternative oxidase confer tolerance to salt stress in maize seedlings. Plant Physiol. Biochem. 2019, 141, 415–422. [Google Scholar] [CrossRef]
- Fridavich, I. Superoxide radical and superoxide dismutases. Annu. Rev. Biochem. 1995, 64, 97–112. [Google Scholar] [CrossRef]
- Wu, C.Y.; Steffen, J.; Eide, D.J. Cytosolic superoxide dismutase (SOD1) is critical for tolerating the oxidative stress of zinc deficiency in yeast. PLoS ONE 2009, 4, e7061. [Google Scholar] [CrossRef]
- Kwast, K.E.; Lai, L.C.; Menda, N.; James, D.T.; Aref, S.; Burke, P.V. Genomic analyses of anaerobically induced genes in Saccharomyces cerevisiae: Functional roles of Rox1 and other factors in mediating the anoxic response. J. Bacteriol. 2002, 184, 250–265. [Google Scholar] [CrossRef] [PubMed]
- Li, S.; Fu, L.; Tian, T.; Deng, L.; Li, H.; Xia, W.; Gong, Q. Disrupting SOD1 activity inhibits cell growth and enhances lipid accumulation in nasopharyngeal carcinoma. Cell Commun. Signal. 2018, 16, 1–13. [Google Scholar] [CrossRef] [PubMed]
- Castello, P.R.; Dong, K.W.; Ball, K.; Wojcik, J.; Liu, L.; Poyton, R.O. Oxygen-regulated isoforms of cytochrome c oxidase have differential effects on its nitric oxide production and on hypoxic signaling. Proc. Natl. Acad. Sci. USA 2008, 105, 8203–8208. [Google Scholar] [CrossRef] [PubMed]
- Liu, J.; Barrientos, A. Transcriptional regulation of yeast oxidative phosphorylation hypoxic genes by oxidative stress. Antioxid. Redox Signal. 2013, 19, 1919–1927. [Google Scholar] [CrossRef] [PubMed]
- Lundgren, C.A.K.; Sjöstrand, D.; Biner, O.; Bennett, M.; Rudling, A.; Johansson, A.L.; Brzezinski, P.; Carlsson, J.; Von Ballmoos, C.; Högbom, M. Scavenging of superoxide by a membrane-bound superoxide oxidase. Nat. Chem. Biol. 2018, 14, 788–793. [Google Scholar] [CrossRef]
- Hampel, M.; Blasco, J.; Martín Díaz, M.L. Biomarkers and Effects. In Marine Ecotoxicology; Academic Press: Cambridge, MA, USA, 2016; pp. 121–165. [Google Scholar]
- Scaglia, N.; Igal, R.A. Stearoyl-CoA desaturase is involved in the control of proliferation, anchorage-independent growth, and survival in human transformed cells. J. Biol. Chem. 2005, 280, 25339–25349. [Google Scholar] [CrossRef]
- Su, L.J.; Zhang, J.H.; Gomez, H.; Murugan, R.; Hong, X.; Xu, D.; Jiang, F.; Peng, Z.Y. Reactive Oxygen Species-Induced Lipid Peroxidation in Apoptosis, Autophagy, and Ferroptosis. Oxid. Med. Cell. Longev. 2019, 2019, 5080843. [Google Scholar] [CrossRef]
- Scaglia, N. Papel de la Estearoil-CoA Desaturasa en el fenotipo celular neoplásico. Ph.D. Thesis, Universidad Nacional de Quilmes, Bernal, Argentina, 2005. [Google Scholar]
- Nasution, O.; Lee, Y.M.; Kim, E.; Lee, Y.; Kim, W.; Choi, W. Overexpression of OLE1 enhances stress tolerance and constitutively activates the MAPK HOG pathway in Saccharomyces cerevisiae. Biotechnol. Bioeng. 2017, 114, 620–631. [Google Scholar] [CrossRef]
- Lopez-Moya, F.; Suarez-Fernandez, M.; Lopez-Llorca, L.V. Molecular mechanisms of chitosan interactions with fungi and plants. Int. J. Mol. Sci. 2019, 20, 332. [Google Scholar] [CrossRef] [PubMed]
- Sellam, A.; Askew, C.; Epp, E.; Lavoie, H.; Whiteway, M.; Nantel, A. Genome-wide Mapping of the Coactivator Ada2p Yields Insight into the Functional Roles of SAGA/ADA Complex in Candida albicans. Mol. Biol. Cell 2009, 20, 2389–2400. [Google Scholar] [CrossRef]
- Dewhurst-Maridor, G.; Abegg, D.; David, F.P.A.; Rougemont, J.; Scott, C.C.; Adibekian, A.; Riezman, H. The SAGA complex, together with transcription factors and the endocytic protein Rvs167p, coordinates the reprofiling of gene expression in response to changes in sterol composition in Saccharomyces cerevisiae. Mol. Biol. Cell 2017, 28, 2637–2649. [Google Scholar] [CrossRef] [PubMed]
- Wolfgert, H.; Manmun, Y.M.; Kuchler, K. The Yeast Pdr15p ATP-binding Cassette (ABC) Protein Is a General Stress Response Factor Implicated in Cellular Detoxification. J. Biol. Chem. 2004, 279, 11593–11599. [Google Scholar] [CrossRef]
- Serratore, N.D.; Baker, K.M.; Macadlo, L.A.; Gress, A.R.; Powers, B.L.; Atallah, N.; Westerhouse, K.M.; Hall, M.C.; Weake, V.M.; Briggs, S.D. A novel sterol-signaling pathway governs azole antifungal drug resistance and hypoxic gene repression in Saccharomyces cerevisiae. Genetics 2018, 208, 1037–1055. [Google Scholar] [CrossRef] [PubMed]
- Hirayama, S.; Sugiura, R.; Lu, Y.; Maeda, T.; Kawagishi, K.; Yokoyama, M.; Tohda, H.; Giga-Hama, Y.; Shuntoh, H.; Kuno, T. Zinc finger protein Prz1 regulates Ca2+ but not Cl− homeostasis in fission yeast. Identification of distinct branches of calcineurin signaling pathway in fission yeast. J. Biol. Chem. 2003, 278, 18078–18084. [Google Scholar] [CrossRef] [PubMed]
- Kappel, L.; Münsterkötter, M.; Sipos, G.; Rodriguez, C.E.; Gruber, S. Chitin and chitosan remodeling defines vegetative development and Trichoderma biocontrol. PLoS Pathog. 2020, 16, e1008320. [Google Scholar] [CrossRef] [PubMed]
- Baker, L.G.; Specht, C.A.; Donlin, M.J.; Lodge, J.K. Chitosan, the deacetylated form of chitin, is necessary for cell wall integrity in Cryptococcus neoformans. Eukaryot. Cell 2007, 6, 855–867. [Google Scholar] [CrossRef]
- Rizzi, Y.S.; Happel, P.; Lenz, S.; Urs, M.J.; Bonin, M.; Cord-Landwehr, S.; Singh, R.; Moerschbacher, B.M.; Kahmann, R. Chitosan and chitin deacetylase activity are necessary for development and virulence of Ustilago maydis. mBio 2021, 12, 1–18. [Google Scholar] [CrossRef]
- Kappel, L.; Gruber, S. Chitin and chitosan—Important structural components in Trichoderma cell wall remodeling. In New and Future Developments in Microbial Biotechnology and Bioengineering; Elsevier: Amsterdam, The Netherlands, 2020; pp. 243–280. [Google Scholar]
- Jiang, X.; Xiang, M.; Liu, X. Nematode-Trapping Fungi. Microbiol. Spectr. 2017, 5, 963–974. [Google Scholar] [CrossRef]
- Rodríguez-Peña, J.M.; García, R.; Nombela, C.; Arroyo, J. The high-osmolarity glycerol (HOG) and cell wall integrity (CWI) signalling pathways interplay: A yeast dialogue between MAPK routes. Yeast 2010, 27, 495–502. [Google Scholar] [CrossRef]
- Zakrzewska, A.; Boorsma, A.; Delneri, D.; Brul, S.; Oliver, S.G.; Klis, F.M. Cellular processes and pathways that protect Saccharomyces cerevisiae cells against the plasma membrane-perturbing compound chitosan. Eukaryot. Cell 2007, 6, 600–608. [Google Scholar] [CrossRef] [PubMed]
- Román, E.; Correia, I.; Prieto, D.; Alonso, R.; Pla, J. The HOG MAPK pathway in Candida albicans: More than an osmosensing pathway. Int. Microbiol. 2020, 23, 23–29. [Google Scholar] [CrossRef] [PubMed]
- Sanz, A.B.; García, R.; Rodríguez-Peña, J.M.; Arroyo, J. The CWI pathway: Regulation of the transcriptional adaptive response to cell wall stress in yeast. J. Fungi 2018, 4, 1. [Google Scholar] [CrossRef] [PubMed]
- Bilsland, E.; Molin, C.; Swaminathan, S.; Ramne, A.; Sunnerhagen, P. Rck1 and Rck2 MAPKAP kinases and the HOG pathway are required for oxidative stress resistance. Mol. Microbiol. 2004, 53, 1743–1756. [Google Scholar] [CrossRef]
- Mollapour, M.; Piper, P.W. Hog1p mitogen-activated protein kinase determines acetic acid resistance in Saccharomyces cerevisiae. FEMS Yeast Res. 2006, 6, 1274–1280. [Google Scholar] [CrossRef]
- Aguilera, J.; Rodriguez-Vargas, S.; Prieto, J.A. The HOG MAP kinase pathway is required for the induction of methylglyoxal-responsive genes and determines methylglyoxal resistance in Saccharomyces cerevisiae. Mol. Microbiol. 2005, 56, 228–239. [Google Scholar] [CrossRef]
- Panadero, J.; Pallotti, C.; Rodríguez-Vargas, S.; Randez-Gil, F.; Prieto, J.A. A downshift in temperature activates the high osmolarity glycerol (HOG) pathway, which determines freeze tolerance in Saccharomyces cerevisiae. J. Biol. Chem. 2006, 281, 4638–4645. [Google Scholar] [CrossRef]
- Winkler, A.; Arkind, C.; Mattison, C.P.; Burkholder, A.; Knoche, K.; Ota, I. Heat stress activates the yeast high-osmolarity glycerol mitogen-activated protein kinase pathway, and protein tyrosine phosphatases are essential under heat stress. Eukaryot. Cell 2002, 1, 163–173. [Google Scholar] [CrossRef] [PubMed]
- Davenport, K.R.; Sohaskey, M.; Kamada, Y.; Levin, D.E.; Gustin, M.C. A second osmosensing signal transduction pathway in yeast: Hypotonic shock activates the PKC1 protein kinase-regulated cell integrity pathway. J. Biol. Chem. 1995, 270, 30157–30161. [Google Scholar] [CrossRef]
- Buehrer, B.M.; Errede, B. Coordination of the mating and cell integrity mitogen-activated protein kinase pathways in Saccharomyces cerevisiae. Mol. Cell. Biol. 1997, 17, 6517–6525. [Google Scholar] [CrossRef] [PubMed]
- Alic, N.; Higgins, V.J.; Pichova, A.; Breitenbach, M.; Dawes, I.W. Lipid Hydroperoxides Activate the Mitogen-activated Protein Kinase Mpk1p in Saccharomyces cerevisiae. J. Biol. Chem. 2003, 278, 41849–41855. [Google Scholar] [CrossRef]
- Scrimale, T.; Didone, L.; De Mesy Bentley, K.L.; Krysan, D.J. The unfolded protein response is induced by the cell wall integrity mitogen-activated protein kinase signaling cascade and is required for cell wall integrity in Saccharomyces cerevisiae. Mol. Biol. Cell 2009, 20, 164–175. [Google Scholar] [CrossRef] [PubMed]

| Fast Growing Monokaryons | ||||||||||||
| Chromosome | Genes ID | Name | PC9 | Mk01 | Mk08 | Mk20 | Mk28 | Mk13 | Mk27 | Mk24 | Mk02 | Mk06 |
| VII | 1113505 | Sod1 | 1.72 | 2.52 | 0.76 | 2.22 | 1.33 | 1.28 | 35.37 | 6.53 | 1.50 | 0.46 |
| VII | 1106868 | Aox | 26.08 | 29.59 | 24.70 | 17.99 | 21.08 | 22.96 | 59.23 | 136.92 | 31.39 | 12.44 |
| VIII | 1113744 | Cyc7 | 580.99 | 1013.51 | 718.25 | 309.61 | 595.12 | 531.36 | 352.51 | 973.96 | 420.19 | 287.56 |
| VIII | 1094413 | Cox5B | 673.80 | 482.00 | 528.72 | 545.66 | 472.96 | 514.22 | 241.54 | 517.18 | 415.76 | 494.22 |
| Slow Growing Monokaryons | ||||||||||||
| Chromosome | Genes ID | Name | Mk74 | Mk61 | Mk75 | Mk76 | Mk77 | Mk69 | Mk82 | Mk62 | Mk83 | PC15 |
| VII | 1113505 | Sod1 | 12.67 | 4.60 | 28.01 | 17.08 | 22.29 | 3.25 | 6.71 | 24.64 | 10.65 | 15.35 |
| VII | 1106868 | Aox | 176.59 | 46.42 | 254.42 | 252.21 | 274.65 | 32.13 | 276.74 | 187.39 | 258.25 | 168.44 |
| VIII | 1113744 | Cyc7 | 1128.50 | 567.12 | 1427.61 | 806.00 | 846.54 | 770.25 | 1202.51 | 555.19 | 1180.23 | 1263.15 |
| VIII | 1094413 | Cox5B | 894.18 | 688.43 | 579.39 | 755.75 | 780.44 | 700.26 | 626.91 | 722.86 | 499.08 | 695.52 |
 | ||||||||||||
Publisher’s Note: MDPI stays neutral with regard to jurisdictional claims in published maps and institutional affiliations. |
© 2021 by the authors. Licensee MDPI, Basel, Switzerland. This article is an open access article distributed under the terms and conditions of the Creative Commons Attribution (CC BY) license (https://creativecommons.org/licenses/by/4.0/).
Share and Cite
Pérez, G.; Lopez-Moya, F.; Chuina, E.; Ibañez-Vea, M.; Garde, E.; López-Llorca, L.V.; Pisabarro, A.G.; Ramírez, L. Strain Degeneration in Pleurotus ostreatus: A Genotype Dependent Oxidative Stress Process Which Triggers Oxidative Stress, Cellular Detoxifying and Cell Wall Reshaping Genes. J. Fungi 2021, 7, 862. https://doi.org/10.3390/jof7100862
Pérez G, Lopez-Moya F, Chuina E, Ibañez-Vea M, Garde E, López-Llorca LV, Pisabarro AG, Ramírez L. Strain Degeneration in Pleurotus ostreatus: A Genotype Dependent Oxidative Stress Process Which Triggers Oxidative Stress, Cellular Detoxifying and Cell Wall Reshaping Genes. Journal of Fungi. 2021; 7(10):862. https://doi.org/10.3390/jof7100862
Chicago/Turabian StylePérez, Gumer, Federico Lopez-Moya, Emilia Chuina, María Ibañez-Vea, Edurne Garde, Luis V. López-Llorca, Antonio G. Pisabarro, and Lucía Ramírez. 2021. "Strain Degeneration in Pleurotus ostreatus: A Genotype Dependent Oxidative Stress Process Which Triggers Oxidative Stress, Cellular Detoxifying and Cell Wall Reshaping Genes" Journal of Fungi 7, no. 10: 862. https://doi.org/10.3390/jof7100862
APA StylePérez, G., Lopez-Moya, F., Chuina, E., Ibañez-Vea, M., Garde, E., López-Llorca, L. V., Pisabarro, A. G., & Ramírez, L. (2021). Strain Degeneration in Pleurotus ostreatus: A Genotype Dependent Oxidative Stress Process Which Triggers Oxidative Stress, Cellular Detoxifying and Cell Wall Reshaping Genes. Journal of Fungi, 7(10), 862. https://doi.org/10.3390/jof7100862










